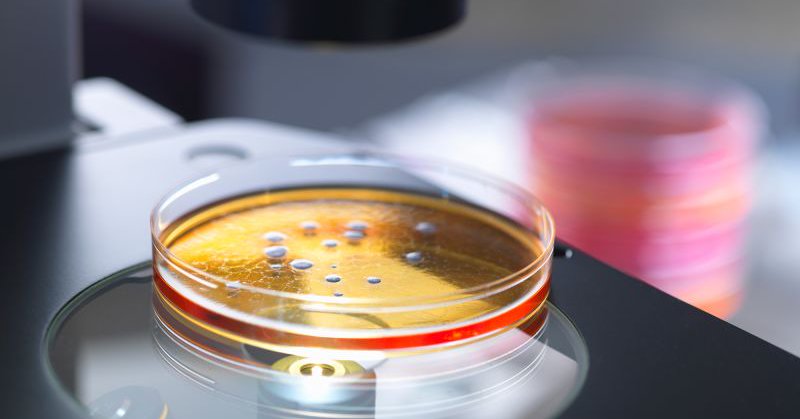

Health
@health
Followers
218K
Following
0
Media
53
Statuses
2K
The latest health news, health product information, deals and more from Writers Write, Inc.
Joined March 2007
Scientists create human eggs from skin cells. Prof Shoukhrat Mitalipov says, "The largest group of patients who might benefit would be women of advanced maternal age."
theguardian.com
Scientists say their early-stage work could help older women or same-sex male couples have children
2
3
5
CDC warns off dramatic increase in a dangerous type of drug-resistant bacteria called NDM-producing carbapenem-resistant Enterobacterales
cdc.gov
A CDC report found a dramatic increase in a dangerous type of drug-resistant bacteria.
0
0
1
American Medical Association’s CEO John Whyte urges U.S. Health Secretary Robert F. Kennedy Jr. not to dismiss the entire Preventive Services Task Force
reuters.com
The panel determines what cancer screenings and other preventive health measures insurers must cover.
11
1
1
The First U.S.-listed ETH + Staking ETF is here. The REX-Osprey ETH + Staking ETF brings spot Ethereum exposure and staking rewards to your brokerage account.
0
3
16
Caltech Researchers Announce Smart Capsule to Measure GI Tract Health. The capsule, called PillTrek, measures 7 millimeters in diameter https://t.co/jhdbhOPfwa
12
9
13
Flashback: Researchers Drop Food on the Floor to Test Five Second Rule - food dropped on carpet was the safest and time does matter
sciencespacerobots.com
Researchers dropped food on different surfaces for short amounts of time to test an urban myth about it being fine to eat food if it has been on the floor for only a few seconds.
6
3
3
Health Deal: The DripDrop Hydration Packets - Juicy Variety Pack is on sale for $25.19 (22% off) at Amazon
amazon.com
DripDrop is a great-tasting electrolyte powder packet that delivers fast hydration more effectively than water alone. DripDrop was developed by Dr. Eduardo Dolhun while on humanitarian aid missions...
0
1
2
I don't have time I have not helped anyone. I am weak. I am one man, My arms don't work. I have to use only my eyes to communicate Through a screen. This is the brutal honestly of having a Terminal illness. BUT I have a purpose. A cause too powerful to ignore has been
1
5
19
Health Deal: The Fitbit Inspire 3 Health &-Fitness-Tracker is on sale for $79.95 (20% off) at Amazon
amazon.com
Do what you love and feel your best with Inspire 3. This little health hack on your wrist helps you stay on top of your stress, fitness and sleep—all you have to do is wear it. Track Health Metrics...
0
1
1
Health Deal: The Amazon Basic Care Extra Strength Pain Relief, Acetaminophen Caplets, 500 mg, 500 Count is on sale for $8.64 (15% off) at Amazon
amazon.com
ACTIVE INGREDIENT: Amazon Basic Care Extra Strength Pain Relief's active ingredient is Acetaminophen, 500 mg, which compares to the active ingredient of Extra Strength Tylenol CapletsAmazon Basic...
3
1
4
Medical researcher and author Eric Topol looks at the breakthroughs and new approaches to longevity in Super Agers
amazon.com
Dr. Topol’s unprecedented, evidenced-based guide is about how you and your family and friends can benefit from new treatments coming available at a faster rate than ever. From his unique position as...
2
2
2
Scientists warn about the possible risks of creating mirror bacteria - "synthetic organisms in which the molecular structure found in nature is reversed"
cnn.com
Experts sounded an alarm about the potentially lethal risks of creating mirror bacteria, synthetic organisms in which the molecular structure found in nature is reversed.
24
9
21
We don’t need new law to build America’s AI bench. We need courage, MOUs, and a 90-day clock.
0
2
35
Black Friday Deal: Amazon has the Oral-B iO Deep Clean Rechargeable Electric Powered Toothbrush for $59.99 (40% off)
shoppersshop.com
Amazon has the Oral-B iO Deep Clean Rechargeable Electric Powered Toothbrush for $59.99 (40% off)
6
1
2
Canada reports first human case of H5 bird flu, teenager hospitalized
bnonews.com
A teenager in the Canadian province of British Columbia has tested positive for H5 bird flu, making it the first human case in the country, according to local officials. The source of the infection...
24
80
230
Grether's Pastilles are a delicious way to remedy a sore throat. The best are the classic blackcurrant pastilles. https://t.co/fy5qqTM3Hk
2
1
3
BREAKING: California reports 2nd human case of bird flu, unrelated to the first
44
734
2K
CVS and FARE Partner for Teal Pumpkin Project. The teal pumpkin is a signal your house offers safe non food treats to help keep Halloween safe for kids with allergies. https://t.co/ycVKkB6A0L
5
3
3
A new study has found that moderate coffee consumption is linked to a lower risk of heart disease, type 2 diabetes and stroke. https://t.co/OsuSg5VPHW Video:
7
9
12
Good Energy: The Surprising Connection Between Metabolism and Limitless Health by Casey Means MD is currently the #1 bestselling book on Amazon
amazon.com
What if depression, anxiety, infertility, insomnia, heart disease, erectile dysfunction, type 2 diabetes, Alzheimer’s, dementia, cancer and many other health conditions that torture and shorten our...
1
2
4
WHO declares new Mpox Outbreak a Global Health Emergency https://t.co/6APUeSbRcb The Clade 1b mpox variant is a more serious, deadlier and faster spreading strain with a death rate of about 3% to 4% in the DRC
2
3
8
A needle-free Epipen alternative has been approved by the FDA. The product is called Neffy. https://t.co/pZELsjytVC
4
3
5
Health Deal: The iHealth No-Touch Forehead Thermometer, Infrared Digital Thermometer is on sale for $15.99 (56% off) at Amazon for Prime Day
amazon.com
Why iHealth Thermometer? 3 Ultra-senstive sensors built-in deliver more reliable results and ultimate safety for the end users. A Ultra-senstive infrared sensor collects more than 100 data points per...
3
0
1